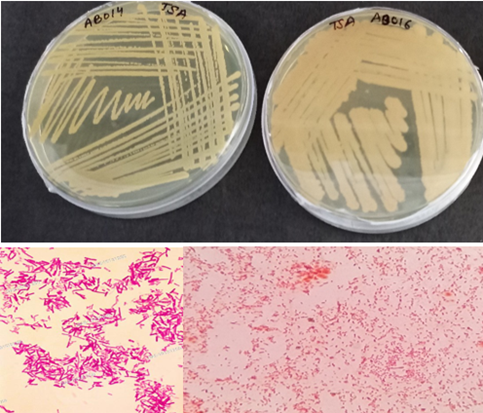

Review Article
Potential Role and Applications of PGPR in Advancing Sustainable Agriculture: Enhancing Plant Growth, Crop Productivity, Soil Health and Stress Tolerance
- Kamal Prasad *
Privi Life Science, Research and Development, A-71, TTC Industrial Area, Thane-Belapur Road, Kopar Khairane, Navi Mumbai, Maharashtra, India.
*Corresponding Author: Kamal Prasad, Privi Life Science, Research and Development, A-71, TTC Industrial Area, Thane-Belapur Road, Kopar Khairane, Navi Mumbai, Maharashtra, India.
Citation: Prasad K. (2025). Potential Role and Applications of PGPR in Advancing Sustainable Agriculture: Enhancing Plant Growth, Crop Productivity, Soil Health and Stress Tolerance, International Journal of Biomedical and Clinical Research, BioRes Scientia Publishers. 4(6):1-16. DOI: 10.59657/2997-6103.brs.25.102
Copyright: © 2025 Kamal Prasad, this is an open-access article distributed under the terms of the Creative Commons Attribution License, which permits unrestricted use, distribution, and reproduction in any medium, provided the original author and source are credited.
Received: October 13, 2025 | Accepted: November 21, 2025 | Published: December 02, 2025
Abstract
Modern agriculture is increasingly challenged by the environmental and health hazards associated with the excessive use of chemical fertilizers and pesticides. These agrochemicals not only contribute to soil degradation and loss of biodiversity but also pose significant health risks to humans, including increased incidence of cancer and endocrine disorders. In response, there is growing interest in sustainable alternatives, particularly the use of biological agents such as plant growth-promoting rhizobacteria (PGPR). PGPR are beneficial soil bacteria that colonize plant roots and stimulate plant growth through a variety of direct and indirect mechanisms. Directly, they enhance nutrient acquisition by fixing atmospheric nitrogen, solubilizing phosphorus, and mobilizing essential micronutrients. They also modulate phytohormone levels, thereby influencing root architecture and overall plant development. Indirectly, PGPR contribute to plant health by suppressing soil-borne pathogens through the production of antibiotics, siderophores, and lytic enzymes, and by inducing systemic resistance in host plants. Furthermore, PGPR interact synergistically or antagonistically with other microbial communities in the rhizosphere and bulk soil, contributing to a balanced soil microbiome that supports plant growth and resilience under both optimal and stress conditions. Numerous studies have demonstrated the effectiveness of PGPR in improving crop productivity, stress tolerance, and soil health across diverse agro-ecological zones. Given their multifaceted roles, PGPR are emerging as viable alternatives to chemical inputs, offering an eco-friendly solution to global food security challenges. However, despite their proven potential, the commercial application of PGPR remains limited due to gaps in understanding their mechanisms of action, environmental adaptability, and formulation strategies. Therefore, further research is essential to optimize PGPR strains, delivery methods, and host-specific interactions to fully harness their capabilities in sustainable agriculture.
Keywords: PGPR; microbiome; biostimulants; rhizosphere; sustainable agriculture; plant-microbe interactions; soil health
Introduction
PGPR as an Effective Strategy for Soil Restoration and Management
Soil erosion and degradation are major threats to global agricultural productivity, particularly in dryland regions. An estimated 3.6 billion hectares of dryland farming areas are currently affected by various forms of soil degradation, including erosion, salinization, nutrient depletion, and contamination (FAO, 2017). These processes significantly reduce soil fertility and hinder crop yields. Both biotic and abiotic factors, such as microbial imbalance, loss of organic matter, salinity, and pollution, contribute to the deterioration of soil quality (Riadh et al., 2010). The use of plant growth-promoting rhizobacteria (PGPR) has emerged as an eco-friendly and sustainable approach for soil restoration. PGPR improve soil health by enhancing its physicochemical and biological properties, even under contaminated or degraded conditions. In polluted soils, the concentration of beneficial microorganisms and essential nutrients is typically low. However, inoculation with PGPR can restore microbial diversity, improve nutrient availability, and promote soil structure and fertility (Bhardwaj et al., 2014, Prasad, 2017; Prasad, 2022a). Due to their high tolerance to stress, pollutant-binding capabilities, and adaptability, PGPR are particularly valuable for remediating contaminated soils. This microbial remediation process, commonly known as rhizoremediation, utilizes the synergistic interaction between plant roots and rhizobacteria to degrade or immobilize pollutants such as pesticides, heavy metals, and polycyclic aromatic hydrocarbons (PAHs) (Burd et al., 2000; Pérez-Montaño et al., 2014). The effectiveness of rhizoremediation depends on several factors, including the type and bioavailability of pollutants, plant species, environmental conditions, and microbial activity (Wenzel, 2009). Recent studies further highlight the potential of PGPR in remediating specific industrial pollutants. Okon et al. (2024) demonstrated that microbial inoculants significantly improved the growth of Amaranthus hybridus in soil contaminated with palm oil mill effluent, showcasing their bioremediation potential. Similarly, PGPR have been successfully used to support plant growth in soils polluted with petroleum hydrocarbons, promoting the growth of crops such as ryegrass, cotton, alfalfa, and tall fescue. In addition to their bioremediation functions, PGPR also serve as biofertilizers and biopesticides, with increasing global demand due to their dual role in enhancing plant productivity and restoring soil health. These bacteria can also promote plant growth under adverse soil conditions, including salinity, heavy metal contamination, and nutrient-deficient soils, making them promising tools in climate-resilient and sustainable agriculture (Vurukonda et al., 2016; Egamberdieva et al., 2017; Prasad, 2017; Prasad, 2022a). Despite these benefits, more research is needed to explore the mechanisms by which PGPR aid in soil restoration and to optimize their application in field conditions. Nonetheless, their potential to simultaneously remediate polluted soils, enhance microbial diversity, and improve plant productivity makes them a cornerstone of modern, sustainable agricultural practices.
Sustainable Agriculture with PGPR for Next Generation: The increasing demand for sustainable agricultural practices has driven interest in biological alternatives to chemical fertilizers and pesticides. Among these, plant growth-promoting rhizobacteria (PGPR) are gaining attention for their ability to enhance plant development, nutrient uptake, and resilience to environmental stress, while simultaneously improving soil health (Prasad, 2022a; b; c; Prasad et al., 2024). In a study by Ahmad et al. (2008), 72 bacterial isolates were obtained from the rhizosphere of legume crops. Of these, only 11 isolates demonstrated multiple plant growth-promoting traits, such as the production of indole-3-acetic acid (IAA), ammonia, hydrogen cyanide (HCN), phosphate solubilization, siderophore production, and antifungal activity. Among the isolates, Azotobacter, Pseudomonas, and Mesorhizobium were found to produce high levels of IAA (up to 80%), whereas Bacillus strains showed comparatively lower IAA production (~20%). The isolates also exhibited varying degrees of phosphate solubilization Bacillus (80%), Azotobacter (74.47%), Pseudomonas (55.56%), and Mesorhizobium (16.67%) highlighting their potential as biofertilizers (Mohanty et al., 2021). Interestingly, all isolates except Mesorhizobium also demonstrated siderophore production and antifungal activity, indicating their role in suppressing plant pathogens through competitive iron chelation and antagonistic interactions. Antifungal assays conducted on Muller–Hinton medium showed that Azotobacter (isolates AZT3, AZT13, AZT23), Pseudomonas (Ps5), and Bacillus (B1) were effective in inhibiting fungal pathogens like Aspergillus, Fusarium, and Rhizoctonia batticaloa (de Andrade et al., 2023).
Further supporting the practical applications of PGPR in sustainable farming, Chowdhury et al. (2016) studied the effects of PGPR on spinach (Spinacia oleracea L.) growth. PGPR isolates were obtained from the rhizospheres of cabbage and paddy plants using serial dilution and biochemical assays (amylase, catalase, and gelatin hydrolysis), followed by PGPR-specific tests for IAA production, phosphate solubilization, HCN, and ammonia production. Four promising isolates SIN1, SIN2, SIN3, and SIN4 (Sample Isolate Nadia) were selected for greenhouse trials. Seeds inoculated with SIN1 showed the highest shoot length (average greater than 3.5 cm), while the combination of all four isolates (SIN1 + SIN2 + SIN3 + SIN4) produced the greatest root length (average greater than 2.5 cm). Additionally, the highest chlorophyll content (greater than 30 mg/g) was recorded in plants treated with SIN1, indicating enhanced photosynthetic capacity and vigor. These results suggest that PGPR can significantly improve seed germination, plant biomass, and physiological performance, and serve as viable substitutes for synthetic fertilizers (Wang et al., 2023a). The use of PGPR in this context demonstrates not only their bio fertilizing potential but also their role as biostimulants and biopesticides, contributing to sustainable agriculture by improving crop performance with minimal environmental impact. As highlighted by Vejan et al. (2016), the integration of PGPR into crop management systems holds promise for reducing the ecological footprint of farming while maintaining or even enhancing productivity.
Plant Health and Soil Fertility for Healthy Ecosystems
Understanding how plant roots interact with their surrounding environment is the first step in the development and application of biofertilizers. These interactions take place in the rhizosphere, the narrow region of soil directly influenced by root secretions and associated microbial activity. A comprehensive understanding of soil composition and function is essential to assess how biofertilizers influence plant growth. Soil is a complex system composed of mineral particles (sand, silt, and clay), organic matter, water, air, and a vast diversity of microorganisms. These components work together to form a medium that supports plant life. The presence of carbon dioxide in soil water helps dissolve mineral particles, releasing nutrients in plant-available forms. In healthy soils, plants and soil organisms actively contribute to the cycling of organic matter and nutrients, ensuring long-term fertility (Sarwar, 2015). A key indicator of plant productivity and food quality is soil health. According to Laishram et al. (2012), soil quality refers to the soil’s capacity to function as a living ecosystem that sustains plants, animals, and humans. Healthy soils allow roots to penetrate easily, retain sufficient moisture, support a diverse microbial community, and are free of harmful contaminants. Such conditions promote vigorous crop growth, high yields, and resistance to pests and diseases. For optimal plant development, the soil must have adequate nutrients, good structure, aeration, and proper drainage. Poor soil conditions, such as compaction, erosion, nutrient imbalances, and pollution, can significantly hinder plant growth and reduce productivity. Unfortunately, soil health is deteriorating globally due to various factors, including Erosion, Loss of organic matter, Soil acidification, Salinization, Waterlogging, Soil compaction, Chemical contamination and Biodiversity loss. These issues often occur together and are interrelated. For instance, soil compaction reduces porosity, which restricts air and water movement, making it difficult for larger soil organisms and plant roots to thrive. Likewise, waterlogging limits oxygen availability and can lead to soil denitrification, severely reducing nitrogen availability for plants (Fu et al., 2021).
Tillage, a common practice in conventional agriculture, also negatively affects soil structure by breaking apart soil aggregates, increasing susceptibility to erosion and reducing organic matter (Fu et al., 2021). In arid and semi-arid regions, the use of saline irrigation water introduces excessive mineral salts, contributing to soil salinization, which disrupts water uptake by plant roots (Liu et al., 2019; Alori et al., 2020). To support sustainable crop production, various soil management practices are being adopted. These include the use of organic amendments, crop rotation, cover cropping, minimum tillage, and the incorporation of beneficial microbes such as PGPR, which enhance soil fertility and suppress plant pathogens (Prasad, 2017; Prasad, 2022a; Prasad, 2024a; b; c). Traditionally, agriculture has relied heavily on chemical fertilizers (CF) to boost soil nutrient levels and pesticides to control pests and diseases. While these inputs have contributed to increased yields, their overuse has resulted in unintended consequences, such as disruption of soil microbial balance, soil structure degradation, groundwater contamination, accumulation of toxic residues, and reduced long-term soil fertility. Montanarella et al. (2016) and Kumar and Pawar (2018), reported that excessive and unbalanced use of agrochemicals is now recognized as a major driver of soil degradation, threatening food security and environmental health. In contrast, the integration of biofertilizers and biological soil amendments, such as PGPR, offers a promising alternative. These microbial solutions promote nutrient cycling, improve soil structure, increase resilience to stress, and reduce dependency on harmful chemicals-paving the way for sustainable and regenerative agriculture.
Next Generation Biofertilizers Derived from PGPR
The limitations and negative impacts of chemical fertilizers and pesticides in conventional agriculture-such as environmental pollution, soil degradation, and reduced biodiversity have accelerated the development of biofertilizers and biopesticides as sustainable alternatives (Figure 1). Among these, biofertilizers derived from PGPR have gained prominence due to their potential to enhance soil fertility and crop productivity in an eco-friendly manner. Biofertilizers are defined as substances containing living microorganisms that, when applied to seeds, plant surfaces, or soil, colonize the rhizosphere or the interior of the plant and promote growth by increasing the availability of essential nutrients (Ortiz and Sansinenea, 2021; Prasad, 2024d; Prasad, 2024a; Prasad, 2025). These microorganisms’ function through several mechanisms, including nitrogen fixation, phosphate solubilization, and the synthesis of plant growth regulators like indole-3-acetic acid (IAA), cytokinins, and gibberellins (Basu et al., 2021; Bhowmik and Das, 2018). Biofertilizers are typically low-cost, renewable, and environmentally friendly, making them a sustainable alternative to synthetic agrochemicals (Husson et al., 2021). Their application not only enhances nutrient cycling and soil fertility but also supports plant health, yield, and resilience to stress.
Different Types of Biofertilizers
Microbial Biofertilizers
- Mycorrhizal Fungi
- Azotobacter spp.
- Azospirillum spp.
- Acetobacter spp.
- Rhizobium spp.
- Fraturia spp.
Non -Microbial Biofertilizers
- Algae Biofertilizers
- Botanical Extracts
- Humic/Fulvic Substances
- Proten Hydrolysates
- Seaweeds Extracts
- Chitosan Base
- Amino Acid-Based
Inorganic Fertilizers
- Cobalt and Silicon
Figure 1: Different types of microbial, nonmicrobial and inorganic biofertilizers.
PGPR as Biofertilizers: PGPR are a key group of free-living soil bacteria that colonize plant roots and stimulate plant growth either directly (by enhancing nutrient availability and hormone production) or indirectly (by suppressing soil pathogens). They are commonly found in the rhizosphere, where they produce a wide array of regulatory compounds, enzymes, and signaling molecules that benefit the host plant (De la Fuente Canto et al., 2020; Basu et al., 2021b; Prasad, 2022a; Prasad, 2024b; Prasad and Pandey, 2024). In agricultural systems, PGPR play a pivotal role such as nitrogen fixation (Azotobacter, Azospirillum, Rhizobium), phosphorus and potassium solubilization, production of siderophores to chelate iron and suppress pathogens, stimulation of root growth and nutrient uptake, and detoxification of harmful substances through bioremediation. PGPR-based biofertilizers are used for a variety of crops:
- Leguminous crops are typically inoculated with Rhizobium spp.
- Cereal crops and vegetables benefit from Azospirillum and Azotobacter
- Sugarcane is often treated with Acetobacter diazotrophicus, known for its nitrogen-fixing ability (Zambrano-Mendoza et al., 2021).
PGPR as Biopesticides and Bioremediators: Many PGPR strains also act as biopesticides, suppressing harmful pathogens through the production of Antibiotics, Lytic enzymes (chitinases, glucanases). Hydrogen cyanide (HCN) and induced systemic resistance (ISR) in plants. Furthermore, PGPR and other beneficial microbes can detoxify organic pollutants, such as pesticide residues and hydrocarbons, and inorganic toxins, such as heavy metals, making them powerful tools for bioremediation of contaminated soils (Tarekegn et al., 2020). This contributes not only to plant and soil health but also to overall ecosystem sustainability.
Table 1: Advantages and Limitations of Microbial Biofertilizers and Biopesticides.
| Category | Advantages | Limitations/Challenges |
| Biofertilizers | Improve nutrient availability to plants (N, P, K). | Short shelf life of microbial strains. |
| Enhance root development and plant growth and productivity. | Sensitivity to storage conditions. | |
| Promote soil fertility and structure. | Inconsistent performance under field conditions. | |
| Environmentally friendly and biodegradable. | Limited awareness and adoption among farmers. | |
| Low cost and renewable resource | Requires crop and soil-specific formulation. | |
| Biopesticides | Target-specific pathogen suppression to all crops. | Narrow pest/pathogen range. |
| Reduce reliance on chemical pesticides save the chemical. | Delayed action compared to chemicals. | |
| Promote plant systemic resistance (ISR). | Regulatory challenges in some countries. | |
| Lower environmental toxicity. | Compatibility issues with chemical inputs. | |
| Help maintain ecological balance. | May require repeated applications. | |
| General | Contribute to sustainable agriculture and organic farming. | Limited commercialization and industrial-scale production. |
| Improve soil biodiversity. | Quality control issues in some markets. | |
| Support bioremediation of contaminants of industrial influents. | High variability due to environmental factors |
Fungal Biofertilizers and Mycorrhizae for Sustainable Agriculture: In addition to bacterial biofertilizers, fungal biofertilizers particularly arbuscular mycorrhizal fungi (AMF) play a vital role in nutrient acquisition, especially phosphorus. These fungi form symbiotic relationships with the roots of most vascular plants, extending hyphae into the soil to access nutrients beyond the depletion zone (Liu et al., 2021; Diagne et al., 2020; Prasad, 2017; Prasad, 2022a; 2024b; Prasad, 2025). Mycorrhizal associations enhance mineral absorption (especially P, Zn, and Cu), improve soil structure, boost plant resistance to pathogens and abiotic stress and increase crop yields and biomass (Mitra et al., 2021; Prasad, 2025).
Challenges in the Use of Microbial Biofertilizer for Sustainable Agriculture: Despite their advantages, microbial biofertilizers face several practical and technical challenges (Table 1) that limit their widespread adoption:
- Strain Selection and Compatibility: Not all strains perform equally across crops and soil types. Effective screening under lab and field conditions is necessary.
- Short Shelf Life and Storage Issues: Many microbial inoculants have limited viability over time, especially under fluctuating temperatures.
- Lack of Technical Knowledge: Farmers may lack awareness or training on proper usage.
- Production and Distribution Barriers: Insufficient infrastructure, funding, and logistics affect product availability and consistency.
- Quality Control Problems: Some commercial products may contain ineffective or non-viable strains, leading to poor performance in the field (Itelima et al. 2018). To be effective, a bioinoculant must survive in the soil environment, be compatible with the target crop, interact positively with the native soil microbiota and withstand environmental stressors such as salinity, drought, and extremes temperature.
Microbial biofertilizers especially those derived from PGPR offer a powerful, sustainable solution for enhancing crop productivity, improving soil health, and reducing environmental impacts associated with chemical inputs. Continued research and development, improved formulation technologies, and farmer education are crucial to overcoming existing barriers and realizing the full potential of biofertilizers in modern agriculture.
Biopesticides Based on PGPR for Sustainable Green Agriculture
Plant pathogens are a major threat to global food production, responsible for the loss of approximately 25-30% of annual crop yields. To address this challenge in a sustainable and environmentally responsible manner, PGPR with biocontrol properties are increasingly being developed as biopesticides.
Role and Types of Biopesticides: Biopesticides are biological formulations derived from living organisms or their natural byproducts (microbial metabolites or phytochemicals) used to suppress pests, pathogens, or weeds (Table 2). These products are target-specific, biodegradable, and less harmful to non-target organisms compared to conventional chemical pesticides (Gupta and Dikshit, 2010). Biopesticides can be broadly categorized into microbial biopesticides derived from bacteria, fungi, viruses, or protozoa, biochemical biopesticides naturally occurring substances like semiochemicals, plant extracts, or enzymes, plant-incorporated protectants (PIPs) substances produced by genetically modified plants (Bt toxins). Among these, microbial biopesticides represent approximately 30% of the global biopesticide market, with bacterial strains being the most dominant group (Thakore, 2006; Kumar and Singh, 2015).
PGPR as Microbial Biopesticides for Next Generation pest Management: PGPR exhibit antagonistic activity against plant pathogens through mechanisms such as:
- Production of antibiotics (phenazines, pyoluteorin).
- Secretion of cell wall-degrading enzymes (chitinases, glucanases).
- Generation of hydrogen cyanide (HCN) and siderophores.
- Induction of systemic resistance (ISR) in host plants.
- Competitive exclusion in the rhizosphere.
Table 2: The most widely used and studied bacterial biopesticide strains for Agriculture.
| Genus | Species/Strains Used | Target Pests/Diseases |
| Bacillus | B. thuringiensis, B. subtilis, B. pumilus | Insect larvae (Lepidoptera), fungi, nematodes |
| Pseudomonas | P. fluorescens, P. putida | Root and foliar pathogens (Fusarium, Rhizoctonia) |
| Streptomyces | S. griseus, S. lydicus | Soil-borne fungal pathogens |
| Burkholderia | B. cepacia complex | Various pathogens |
| Agrobacterium | A. radiobacter K84 | Crown gall disease in fruit crops |
| Azospirillum | Used more for growth promotion, but with ISR potential | Biotic stress tolerance |
Among these, Bacillus thuringiensis (Bt) remains the most commercially successful bacterial biopesticide, accounting for over 95% of all biopesticide products in use globally. It produces cry proteins that are toxic to specific insect larvae and has been used effectively in pest control since the 1960s, notably in products like Thuricide (Bravo et al., 2011; Fravel, 2005).
Global Market Trends and Growth for Sustainable Agriculture: The biopesticide industry has experienced significant growth in recent decades, reflecting a shift toward more sustainable crop protection practices. According to BCC Research and PR Newswire:
- Global biopesticide sales were USD 10.12 billion in 2025, rising to USD 11.12 billion in 2026.
- The market value reached USD 13.90 billion in 2028 and USD 15.66 billion in 2029.
- A compound annual growth rate (CAGR) of 14.1% was projected from 2016-2021.
- The market is expected to surpass ~ USD 18.2 billion by 2030, with continued growth driven by regulatory restrictions on synthetic pesticides, increasing awareness of environmental health and growth in organic farming sectors.
The adoption of PGPR-based biopesticides is gaining traction globally due to their high efficacy in disease suppression, ability to enhance plant immunity, compatibility with integrated pest management (IPM) systems and reduced environmental impact.
Challenges in Biopesticide Use for Sustainable Agriculture: Despite their advantages, the commercial use of PGPR-based biopesticides faces some challenges such as limited shelf life and sensitivity to environmental conditions, field performance inconsistency under different agroclimatic zones, regulatory hurdles and registration processes, high production costs in comparison to chemical counterparts and farmer awareness and training gaps. To overcome these barriers, research is focused on developing formulation technologies that improve viability and shelf life, screening for broad-spectrum and stress-tolerant strains and enhancing delivery methods such as encapsulation or biofilm-based inoculants. PGPR-based biopesticides represent a promising alternative to synthetic pesticides, offering targeted, eco-friendly, and sustainable crop protection. With advancements in biotechnology, improved formulations, and growing market demand, these microbial products are poised to play a central role in future integrated pest management systems and sustainable agriculture.
Mechanisms for the Promotion of Plant Growth for Future Generation
Plant growth-promoting rhizobacteria (PGPR) facilitate plant development through a variety of direct and indirect mechanisms, which enhance nutrient uptake, stimulate plant hormone production, improve stress tolerance, and suppress phytopathogens. These mechanisms are diverse and often occur simultaneously in the rhizosphere, making PGPR versatile tools in sustainable agriculture.
Direct Mechanisms: The direct mechanisms employed by PGPR involve activities that improve plant nutrition and hormonal regulation:
- Biological Nitrogen Fixation: Certain PGPR, such as Azospirillum and Rhizobium, convert atmospheric nitrogen (N₂) into ammonia (NH₃), a form accessible to plants (Boonjawat et al., 1991; Elmerich et al., 1992; Dobereiner et al., 1995, Prasad, 2022d). This process significantly enhances plant nitrogen nutrition, particularly in nitrogen-deficient soils.
- Production of Phytohormones: Several PGPR produce plant hormones such as indole-3-acetic acid (IAA), cytokinins, and gibberellins, which regulate plant cell division, elongation, and differentiation. These hormones contribute to better root architecture and increased biomass (Arshad and Frankenberger, 1998).
- Enhanced Root Development: PGPR can increase root surface area and the number of root hairs, improving water and nutrient uptake. This is often associated with hormonal changes and improved soil structure (Bowen and Rovira, 1999).
- Phosphate and Potassium Solubilization: Some species, such as Bacillus megaterium and Bacillus circulans, release organic acids or enzymes that convert insoluble forms of phosphorus and potassium into bioavailable forms, thus enhancing nutrient uptake (Bashan et al., 1996).
- Siderophore Production: Siderophores are low-molecular-weight compounds that chelate iron (Fe³⁺) from the soil and make it available to plants, especially under iron-deficient conditions. This also limits iron availability to pathogenic microbes (Crowley et al., 1991).
- Modification of Root Membrane Potential: Some bacteria can influence ion transport and nutrient absorption by modifying the electrical potential across root cell membranes, which may improve mineral uptake (Bashan and Levanony, 1991).
Indirect Mechanisms: PGPR also protect plants against stress and disease through indirect mechanisms, which include:
- Biological Control of Pathogens: Some PGPR strains, particularly Bacillus subtilis and Pseudomonas fluorescens, produce antibiotics, lytic enzymes, and volatile organic compounds (VOCs) that inhibit the growth of phytopathogens (Utkhede et al., 1991; Bashan et al., 1996, Prasad, 2022d).
- Induced Systemic Resistance (ISR): PGPR can activate a plant’s defense mechanisms, making it more resistant to a broad spectrum of pathogens without the presence of an actual infection. This ISR is often triggered by Pseudomonas and Bacillus species (Van Peer et al., 1991).
- Synergistic Interactions: PGPR can interact positively with other beneficial microbes, such as mycorrhizal fungi or nitrogen-fixing bacteria, forming complex microbial consortia that support plant health and productivity (Bashan et al., 1996, Prasad, 2022a).
Multifunctional PGPR: Many PGPR exhibit multiple growth-promoting traits, allowing them to contribute to plant development through several pathways simultaneously. For example: Azospirillum spp. not only fix atmospheric nitrogen but also produce auxins and other hormones. They can also influence root membrane function via signal molecules, supporting the “additive hypothesis,” where multiple mechanisms act together to benefit plant growth (Bashan et al., 1996a). Bacillus spp., including B. subtilis, B. polymyxa, and B. circulans, are widely studied for their biocontrol properties, antibiotic production, phosphate solubilization, and nitrogen fixation capabilities (Bashan et al., 1996). These multifunctional characteristics make PGPR effective biofertilizers, biopesticides, and biostimulants, particularly under challenging environmental conditions (Figure 2).
Visual Representation of PGPR Mechanisms
Figure 2: Conceptual Diagram: Role of PGPR as Biofertilizers and Biopesticides.
Production of Growth-Regulating Substances by PGPR
While early research on rhizosphere bacteria focused primarily on their ability to fix atmospheric nitrogen, more recent studies have highlighted their equally important role in synthesizing growth-regulating substances (Arshad and Frankenberger, 1998). These low-molecular-weight compounds, often referred to as phytohormones or plant growth regulators (PGRs), play a pivotal role in modulating plant growth and development, even at very low concentrations (Prasad, 2022c).
Plant Growth Regulators Produced by PGPR: There are five major classes of plant hormones that regulate physiological processes in plants such as Auxins (indole-3-acetic acid, IAA), Gibberellins, Cytokinins, Ethylene and Abscisic acid (ABA). These hormones are naturally produced by plants, but several PGPR are also capable of synthesizing these compounds in the rhizosphere. In this context, they are often referred to as microbial plant growth regulators, which may interact synergistically or antagonistically with the plant’s endogenous hormone system (Arshad and Frankenberger, 1991; 1998; Prasad, 2025).
Mechanisms of Hormone Production and Plant Interaction: The production of these growth-promoting substances by bacteria is often triggered by root exudates from the host plant. Azotobacter chroococcum can produce indole-3-acetic acid (IAA) from tryptophan, a common root exudate (Brown, 1972), When grown in nitrogen-free media supplemented with corn root exudates, A. chroococcum also synthesizes auxins, gibberellins, and cytokinins (Martinez et al., 1988) and Cytokinin production by PGPR is often enhanced when supplemented with precursors like adenine (ADE) and isopentenyl alcohol (AI) (Arshad and Frankenberger, 1991; Nieto and Frankenberger, 1991). Arshad and Frankenberger (1998) proposed a model that illustrates how microbial-produced IAA and plant-produced IAA can collectively influence plant physiology. In this model, microbial IAA (from PGPR colonizing the seed or root surface) is absorbed by the plant and either promotes cell elongation and division or induces the production of 1-aminocyclopropane-1-carboxylic acid (ACC) via activation of the enzyme ACC synthase. ACC is the immediate precursor to ethylene, a stress hormone that, in excess, can inhibit plant growth. Interestingly, some PGPR produce ACC deaminase, an enzyme that degrades ACC into α-ketobutyrate and ammonium, thereby reducing ethylene levels within the plant (Dobbelaere et al., 1999). This process not only supports bacterial nitrogen acquisition but also reduces ethylene-induced stress in plants-leading to improved root elongation, biomass accumulation, and enhanced root hair development, which increases ion permeability and nutrient uptake (Chalk, 1991).
Impacts of Biofertilizers in Sustainable Agriculture
- Approximately 93% of Azotobacter isolates from grasses have been reported to produce auxins, highlighting their strong growth-promoting potential (Arshad and Frankenberger, 1998).
- Culture supernatants of A. chroococcum have shown the presence of IAA, as well as unidentified derivatives of auxins and gibberellins, indicating the multifactorial nature of bacterial influence on plant growth (Arshad and Frankenberger, 1998).
- However, it is important to note that IAA production is not exclusively beneficial. Certain plant-pathogenic bacteria also produce IAA as a mechanism to manipulate host plant physiology, promoting infection and disease progression (Fett et al., 1987; Schippers et al., 1987; Gaudin et al., 1994). This underlines the need for continued research to differentiate beneficial PGPR strains from pathogenic counterparts.
The ability of PGPR to produce growth-regulating substances represents a key mechanism through which they influence plant development. These microbial hormones especially IAA, gibberellins, and cytokinins promote cell division, elongation, and nutrient acquisition. Additionally, the modulation of ethylene levels via ACC deaminase activity provides protection from stress and enhances root system architecture. These multifaceted interactions make PGPR invaluable tools in sustainable crop production, particularly under abiotic stress conditions.
Nutrient Solubilization and Siderophore Production
Beyond nitrogen fixation and phytohormone production, PGPR also contribute to plant development by enhancing nutrient availability, particularly through mineral solubilization and siderophore production. These mechanisms help plants acquire essential nutrients especially in soils with poor nutrient availability or under abiotic stress conditions.
Rhizospheric Microbial Interactions and Nutrient Competition: Although microorganisms in the rhizosphere may compete with plants for nutrients by immobilizing mineral elements or consuming plant exudates many PGPR have evolved mechanisms that improve plant mineral nutrition (Wiren et al., 1993). For example, specific bacteria secrete compounds that chelate and solubilize otherwise unavailable forms of nutrients, such as iron (Fe), phosphorus (P), and potassium (K), making them accessible for plant uptake.
Organic Acids and Root Exudates in Response to Stress: Under nutrient-deficient conditions particularly iron deficiency plants respond by releasing organic acids and other exudates into the rhizosphere. These exudates not only mobilize nutrients but also shape the rhizospheric microbial community (Crowley et al., 1988; Jones et al., 1996). The distribution of bacteria in the root zone is strongly influenced by such plant-mediated responses, especially in relation to iron availability (Yang and Crowley, 2000).
Role and Mechanism of Siderophores: Siderophores are low-molecular-weight, high-affinity iron-chelating compounds produced by both plants and microorganisms. They play a critical role in iron acquisition, especially in iron-limited soils where Fe³⁺ is poorly soluble (Yang and Crowley, 2000). Among PGPR, species of Pseudomonas, Azospirillum, and Azotobacter are well-known siderophore producers (Zdor and Anderson, 1992). In a study on Pseudomonas 7NSK (a strain of P. aeruginosa), inoculation led to yield improvements in barley, maize, and corn. The enhanced crop performance was attributed to the production of Pyoverdin, a fluorescent siderophore. Pyoverdin is synthesized under iron-deficient conditions, low pH, or in response to fungal pathogens, serving both as a nutrient acquisition tool and a biocontrol agent against soilborne pathogens (Hofte et al., 1991).
Metal Interactions and Siderophore Competition: Recent research has shown that molybdenum nitrogenase activity in Azotobacter vinelandii is linked to siderophore production. These siderophores form complexes with various trace metals, including molybdenum, vanadium, tungsten, zinc, and manganese, depending on their structure and ligand affinity (Cornish and Page, 2000). Interestingly, while Fe³⁺ can displace other metals from siderophore complexes, the accumulation of siderophores in A. vinelandii appears more strongly influenced by trace metal interference not just iron competition. Some metals likely inhibit ferric reductase enzymes, disrupting iron release from siderophores and triggering further siderophore synthesis. In Azospirillum lipoferum, phenolate-type siderophores and salicylic acid have been identified, suggesting a dual role in iron acquisition and plant defense. Similarly, in Azotobacter and Azospirillum, siderophore production is linked to the expression of outer membrane proteins involved in iron transport and cellular uptake (Elmerich et al., 1992a). Siderophore production is a critical trait of many PGPR that enhances iron availability and supports plant growth, especially in iron-deficient or alkaline soils. In addition to acting as micronutrient solubilizers, siderophores contribute to biocontrol by inhibiting phytopathogens through competitive iron sequestration. The interplay between microbial siderophores, plant exudates, and trace metal interactions adds complexity to rhizosphere dynamics but presents promising opportunities for sustainable agriculture.
Alterations in Membrane Potential and Microbial Interactions in the Rhizosphere
In addition to enhancing nutrient availability and producing growth-promoting substances, rhizobacteria can influence plant physiology by altering the membrane potential of root cells and promoting proton efflux into the rhizosphere. This physiological modulation plays a crucial role in nutrient uptake, root development, and overall plant health.
Membrane Potential Changes Induced by PGPR: One well-documented example involves Azospirillum brasilense, which can induce proton release from wheat roots, thereby acidifying the rhizosphere. In a microscopic study, A. brasilense was observed to interact closely with wheat root epidermal cells, although direct contact with the plasma membrane was prevented by the cell wall (Bashan and Levanony, 1991). Despite this, the bacterium was able to trigger changes in proton flux, indicating the release of a bacterial signal molecule capable of penetrating the plant cell wall and altering root membrane potential. In non-inoculated wheat, proton release and pH changes followed a bimodal distribution, alternating between acidic and alkaline phases. However, after inoculation with Azospirillum, proton release became constant, stabilizing the rhizosphere pH at 3.1 ± 0.1 throughout a 200-hour monitoring period. Bashan and Levanony (1991) proposed that this steady acidification was caused by a signaling compound produced by the bacterium that affects membrane activity particularly in the elongation zone of roots. Although the exact nature of this signal remains uncharacterized, it clearly plays a role in modifying root physiology and nutrient availability.
Synergistic Interactions with Other Microorganisms: PGPR not only interact with plants but also engage in synergistic relationships with other soil microbes, including nitrogen-fixing bacteria, fungi, and cellulolytic organisms. These interactions can enhance the efficiency of nutrient cycling and plant growth. Azotobacter chroococcum, a free-living diazotroph, has shown improved nitrogen fixation when co-cultured with other microorganisms such as Agrobacterium, Aerobacter, Clostridium, and cellulolytic fungi (Jensen and Holm, 1975). Such co-associations facilitate nutrient exchange, enzyme complementation, and root colonization, enhancing microbial persistence and activity in the rhizosphere.
Bacillus and Azospirillum Synergy: Bacillus species are particularly notable for forming beneficial consortia with other PGPR. In a study on sorghum, co-inoculation of Bacillus polymyxa with Azospirillum brasilense resulted in a 46% increase in grain yield and a 52% increase in phosphorus uptake, compared to plants inoculated with either bacterium alone (Bashan et al., 1996). This demonstrates the additive or even synergistic effect of using multiple PGPR species, which likely function via complementary modes of action, such as phosphate solubilization, nitrogen fixation, and hormone production.
Interactions with Mycorrhizal Fungi: Rhizobacteria can also interact synergistically with vesicular-arbuscular mycorrhizae (VAM) fungi. For instance, Acetobacter diazotrophicus and Klebsiella spp. have been isolated from spores of the mycorrhizal fungus Glomus clarum, indicating a close association. Inoculation experiments on crops such as potato, sorghum × Sudan grass hybrids, and sugarcane using a combination of these bacteria and the mycorrhizal fungus resulted in significantly higher colonization by diazotrophs on plant roots compared to single inoculation treatments (Paula et al., 1991). These findings suggest that such microbial consortia can enhance root colonization, nutrient uptake, and crop productivity through cooperative interactions. PGPR like Azospirillum and Bacillus can significantly impact plant root physiology by modifying membrane potential and acidifying the rhizosphere, which enhances nutrient solubility and uptake. Moreover, their ability to form synergistic associations with other beneficial microorganisms including nitrogen fixers and mycorrhizal fungi—further amplifies their plant growth-promoting effects. These findings highlight the potential of using microbial consortia for sustainable crop production.
Synergistic Interactions Between PGPR and Mycorrhiza in the Rhizosphere
The rhizosphere, a narrow zone of soil surrounding plant roots, serves as a dynamic interface where complex interactions occur between plants, microbes, and soil particles. Among the most significant microbial partners in this zone are PGPR and mycorrhizal fungi. Together, they form synergistic associations that can significantly enhance plant health, growth, nutrient uptake, and stress tolerance (Smith and Read, 2008, Prasad, 2017; 2022a; 2024; 2025).
Mycorrhiza as a Type of PGPR: Although mycorrhizal fungi are traditionally classified separately from bacteria, they function in a plant growth-promoting capacity similar to PGPR. Specifically, arbuscular mycorrhizal fungi (AMF) form symbiotic relationships with nearly 90% of terrestrial plants. These fungi colonize root cortical cells, forming structures like arbuscules and vesicles, which facilitate nutrient exchange between the plant and fungus. In return for photosynthetically derived carbon from the host plant, mycorrhizal fungi significantly increase phosphorus (P), zinc (Zn), copper (Cu), and water uptake (Figure 3), especially under nutrient-deficient or drought-prone conditions (Smith and Smith, 2011; Prasad, 2017; Prasad, 2022a; Prasad, 2025). Thus, AMF are often considered functional PGPR analogs, especially when they are co-inoculated with beneficial rhizobacteria such as Azospirillum, Pseudomonas, or Bacillus, creating a synergistic effect that surpasses their individual benefits.
Figure 3: Mycorrhizal biofertilizers benefits and significance in Agriculture.
Synergistic Interactions in the Rhizosphere: Co-inoculation of PGPR and mycorrhizae can lead to a mutually reinforcing relationship:
- PGPR enhance root exudation and modify the rhizosphere environment, creating favorable conditions for mycorrhizal colonization.
- Some PGPR strains secrete mycorrhiza-helper compounds such as indole-3-acetic acid (IAA), siderophores, and lytic enzymes that promote fungal hyphal growth (Frey-Klett et al., 2007).
- Mycorrhizae, in turn, expand the effective root surface area, thereby increasing the zone of influence for PGPR, facilitating better nutrient and water access.
- Together, they improve nutrient solubilization, induce systemic resistance (ISR) against pathogens, and enhance plant tolerance to abiotic stresses such as salinity, drought, and heavy metal toxicity (Ortíz-Castro et al., 2009).
Practical Applications and Outcomes: In agricultural systems, co-inoculation strategies have shown promising outcomes. For instance, the combined use of AMF (Glomus spp.) and PGPR (Azospirillum brasilense) in crops like maize, wheat, and legumes has led to improved plant biomass, nutrient content, chlorophyll levels, and disease resistance (Bashan et al., 2005). These synergistic inoculants are now being developed as bioformulations for sustainable, low-input farming systems. Such dual microbial applications can also revitalize degraded soils, restore microbial biodiversity, and reduce the dependency on chemical fertilizers and fungicides, aligning with the goals of climate-smart and organic agriculture. For decades, farmers have relied heavily on chemical fertilizers and pesticides to boost soil fertility and protect crops. While these agrochemicals have improved productivity in the short term, their long-term environmental and health consequences including soil degradation, water pollution, biodiversity loss, and food contamination have raised global concerns (Kumar and Pawar, 2018; Montanarella et al., 2016). In response to increasing awareness around food safety, environmental sustainability, and the rising consumer demand for organic and residue-free produce, the agricultural sector is shifting toward ecologically sound practices. One such strategy is the use of biofertilizers and biopesticides, particularly those derived from Plant Growth-Promoting Rhizobacteria (PGPR). PGPR play a vital role in sustainable agriculture by enhancing soil fertility, improving plant growth, and protecting crops through biological nitrogen fixation, phosphate solubilization, siderophore production, synthesis of phytohormones, and antagonistic activity against pathogens (Vejan et al., 2016; Basu et al., 2021b). These microbes support the establishment of resilient agroecosystems that maintain high crop productivity without causing environmental harm.
PGPR help build a healthy soil structure, promote a diverse and thriving microbial community, ensure nutrient availability, enhance plant defense mechanisms, and minimize reliance on synthetic inputs. The application of PGPR-based biofertilizers and biopesticides offers a sustainable and cost-effective alternative to chemical inputs. They not only boost yield and quality but also improve soil health over time, restore microbial balance, and help suppress soil-borne pests and diseases naturally (Itelima et al., 2018). however, despite their proven benefits, challenges remain in the broader adoption of PGPR products. These include Strain specificity and environmental adaptability, short shelf life and inconsistent field performance, Lack of farmer awareness, Insufficient infrastructure for production and distribution, and need for supportive policies and extension services (Husson et al., 2021a, b). To fully realize the potential of PGPR in agriculture, it is essential to invest in targeted research for strain development, improved formulation technologies, farmer education and training, and robust regulatory frameworks to ensure product quality and efficacy. Incorporating PGPR into integrated soil fertility and pest management strategies represents a holistic approach to farming one that aligns with the goals of climate-smart, sustainable agriculture and global food security. With continued research and implementation support, PGPR-based solutions can be a cornerstone in the transition to ecologically responsible farming systems. The synergistic interaction between PGPR and mycorrhizae in the rhizosphere represents a powerful natural alliance that can be harnessed for sustainable crop production. These microorganisms not only enhance nutrient uptake and plant vigor but also improve soil structure and ecological balance. As research progresses, developing multi-strain biofertilizer formulations that include both PGPR and AMF will be essential for achieving resilient agricultural systems in the face of global environmental challenges.
Conclusions
PGPR offer a promising, eco-friendly alternative to chemical fertilizers and pesticides in modern agriculture. By enhancing nutrient availability, stimulating plant growth, and providing natural protection against pests and diseases, PGPR contribute significantly to sustainable crop production and soil health. Their synergistic interactions with other beneficial soil microbes, such as AM fungi, further strengthen plant resilience and ecosystem stability. However, despite their proven benefits, widespread adoption of PGPR-based biofertilizers and biopesticides remains limited due to several challenges. These include strain specificity and environmental variability, short shelf life, inconsistent performance in the field, limited farmer awareness, and inadequate infrastructure for large-scale production and distribution. Addressing these barriers requires coordinated efforts in research, policymaking, and farmer outreach. Investments in the development of robust and adaptable microbial strains, improved formulation and delivery technologies, and comprehensive extension services are essential. Moreover, the integration of PGPR into holistic soil fertility and pest management strategies can support climate-resilient and sustainable agriculture. As the demand for environmentally sound and residue-free farming practices grows, PGPR-based solutions have the potential to play a pivotal role in ensuring global food security and ecological balance.
Declarations
Competing Interests
The author has declared that no competing interests exist.
Ethical Approval
Not applicable.
Consent to Participate
Not applicable.
References
- Ahmad, F., Ahmad, I., Khan, M. S. (2008). Screening of free-living rhizospheric bacteria for their multiple plant growth promoting activities. Microbiological Research, 163(2):173-181.
Publisher | Google Scholor - Alori, E. T., Adekiya, A. O., Adegbite, K. A. (2020). Impact of agricultural practices on soil health. In B. Giri & A. Varma (Eds.), Soil Health, 59:1-20.
Publisher | Google Scholor - Arshad, M., Frankenberger, W. T. (1991). Microbial production of plant hormones. Plant and Soil, 133(1):1-8.
Publisher | Google Scholor - Arshad, M., Frankenberger, W. T. (1998). Plant growth-regulating substances in the rhizosphere: Microbial production and functions. Advances in Agronomy, 62:45-151.
Publisher | Google Scholor - Bashan, Y., Levanony, H. (1991). Changes in membrane potential of soybean root cells induced by Azospirillum brasilense. Canadian Journal of Microbiology, 37(7):561-567.
Publisher | Google Scholor - Bashan, Y., Levanony, H. (1991). Alterations in membrane potential and in proton efflux in plant roots induced by Azospirillum brasilense. Plant and Soil, 137(1):99-103.
Publisher | Google Scholor - Bashan, Y., de-Bashan, L. E., Prabhu, S. R., Hernandez, J. P. (2014). Advances in plant growth-promoting bacterial inoculant technology: formulations and practical perspectives (1998–2013). Plant and Soil, 378(1-2):1-33.
Publisher | Google Scholor - Bashan, Y., Holguin, G., de-Bashan, L. E. (1996). Co-inoculation of Bacillus polymyxa and Azospirillum brasilense increases growth and nutrient uptake in sorghum. Biology and Fertility of Soils, 23(3):243-248.
Publisher | Google Scholor - Bashan, Y., Holguin, G., de-Bashan, L. E. (1996). Azospirillum–plant relationships: Physiological, molecular, agricultural, and environmental advances. Canadian Journal of Microbiology, 42(8):561-575.
Publisher | Google Scholor - Bashan, Y., Holguin, G., de-Bashan, L. E. (2005). Plant growth-promoting bacteria: mechanisms and applications. Critical Reviews in Plant Sciences, 24(6):423-460.
Publisher | Google Scholor - Basu, A., Prasad, P., Das, S. N., Kalam, S., Sayyed, R. Z., et al. (2021). Perspectives on plant growth-promoting rhizobacteria as bioinoculants for sustainable agriculture. Frontiers in Microbiology, 12:634422.
Publisher | Google Scholor - Basu, A., Prasad, P., Das, S. N., Kalam, S., Sayyed, R. Z., et al. (2021). Plant growth promoting rhizobacteria (PGPR) as green bioinoculants: Recent developments, constraints, and prospects. Sustainability, 13(3):1140.
Publisher | Google Scholor - Bhardwaj, D., Ansari, M. W., Sahoo, R. K., Tuteja, N. (2014). Biofertilizers function as key player in sustainable agriculture by improving soil fertility, plant tolerance and crop productivity. Microbial Cell Factories, 13(1):66.
Publisher | Google Scholor - Bhowmik, S. N., Das, A. (2018). Biofertilizers: A sustainable approach for pulse production. In R. S. Meena, A. Das, G. S. Yadav, & R. Lal (Eds.), Legumes for soil health and sustainable management, 1-20.
Publisher | Google Scholor - Boonjawat, J., Chaisiri, P., Limpananont, J., Soontaros, S., Pongsawasdi, P., et al. (1991). Biology of nitrogen-fixing rhizobacteria. Plant and Soil, 137(1):119-125.
Publisher | Google Scholor - Boonjawat, J., Döpereiner, J., Urquiaga, S. (1991). Nitrogen fixation associated with roots of tropical grasses. Soil Biology and Biochemistry, 23(5):449-454.
Publisher | Google Scholor - Bowen, G. D., Rovira, A. D. (1999). The rhizosphere and its management to improve plant growth. Advances in Agronomy, 66:1-102.
Publisher | Google Scholor - Bravo, A., Likitvivatanavong, S., Gill, S., Soberon, M. (2011). Bacillus thuringiensis: A story of a successful bio-insecticide. Insect Biochemistry and Molecular Biology, 41(7):423-431.
Publisher | Google Scholor - Brown, M. E. (1972). Plant growth substances produced by microorganisms in soil and rhizosphere. Journal of Applied Bacteriology, 35(3):443-451.
Publisher | Google Scholor - Burd, G. I., Dixon, D. G., Glick, B. R. (2000). Plant growth-promoting bacteria that decrease heavy metal toxicity in plants. Canadian Journal of Microbiology, 46(3):237-245.
Publisher | Google Scholor - Chalk, P. M. (1991). The contribution of associative and symbiotic nitrogen fixation to the nitrogen nutrition of non-legumes. Plant and Soil, 132(1):29-39.
Publisher | Google Scholor - Chowdhury, R. A., Bagchi, A., Sengupta, C. (2016). Isolation and characterization of plant growth promoting rhizobacteria (PGPR) from agricultural field and their potential role on germination and growth of spinach (Spinacia oleracea L.) plants. International Journal of Current Agricultural Sciences, 6(10):128-131.
Publisher | Google Scholor - Cornish, A. S., Page, W. J. (2000). Role of siderophores in metal uptake in Azotobacter vinelandii. Journal of Bacteriology, 182(3):670-678.
Publisher | Google Scholor - Crowley, D. E., Reid, C. P. P., Szaniszlo, P. J. (1988a). Utilization of microbial siderophores in iron acquisition by oat. Plant Physiology, 87(3):680-685.
Publisher | Google Scholor - Crowley, D. E., Wang, Y. C., Reid, C. P. P., Szaniszlo, P. J. (1991). Mechanisms of iron acquisition from siderophores by microorganisms and plants. Plant and Soil, 130(1):179-198.
Publisher | Google Scholor - de Andrade, L. A., Santos, C. H. B., Frezarin, E. T., Sales, L. R., Rigobelo, E. C. (2023). Plant growth-promoting rhizobacteria for sustainable agricultural production. Microorganisms, 11(4):1088.
Publisher | Google Scholor - De la Fuente Canto, C., Simonin, M., King, E., Moulin, L., Bennett, M. J., et al. (2020). An extended root phenotype: The rhizosphere, its formation and impacts on plant fitness. The Plant Journal, 103(3):951-964.
Publisher | Google Scholor - Diagne, N., Ngom, M., Djighaly, P. I., Fall, D., Hocher, V., et al. (2020). Roles of arbuscular mycorrhizal fungi on plant growth and performance: Importance in biotic and abiotic stressed regulation. Diversity, 12(10):370.
Publisher | Google Scholor - Dobbelaere, S., Croonenborghs, A., Thys, A., Vande Broek, A., Vanderleyden, J. (1999). Phytostimulatory effect of Azospirillum brasilense wild type and mutant strain altered in IAA production on wheat. Plant and Soil, 212(1):155-164.
Publisher | Google Scholor - Dobereiner, J., Urquiaga, S., Boddey, R. M., Ahmad, N. (1995). Alternatives for nitrogen nutrition of crops in tropical agriculture. Fertilizer Research, 42(1-3):339-346.
Publisher | Google Scholor - Mishra J., Prakash, J., Arora, N. (2017). Role of beneficial microbes in sustainable agriculture and environmental management. Microbiological Research, 206:1-2.
Publisher | Google Scholor - Elmerich, C., Rincón, A., Jouanin, L. (1992). Regulation of nitrogen fixation and other physiological traits in Azospirillum and Azotobacter. Plant and Soil, 145(1):63-73.
Publisher | Google Scholor - Elmerich, C., Rincón, A., Jouanin, L. (1992). Genetics of nitrogen fixation in free-living rhizobacteria and associative symbionts. Plant and Soil, 141(1-2):93-103.
Publisher | Google Scholor - FAO. (2017). The Future of Food and Agriculture - Trends and Challenges. Food and Agriculture Organization of the United Nations.
Publisher | Google Scholor - Fett, W. F., Osman, S. F., Dunn, M. F. (1987). Auxin production by plant-pathogenic pseudomonads and xanthomonads. Applied and Environmental Microbiology, 53(8):1839-1845.
Publisher | Google Scholor - Fravel, D. R. (2005). Commercialization and implementation of biocontrol. Annual Review of Phytopathology, 43:337-359.
Publisher | Google Scholor - Frey-Klett, P., Garbaye, J., Tarkka, M. (2007). The mycorrhiza helper bacteria revisited. New Phytologist, 176(1):22-36.
Publisher | Google Scholor - Fu, B., Chen, L., Huang, H., Qu, P., Wei, Z. (2021). Impacts of crop residues on soil health: A review. Environmental Pollution and Bioavailability, 33(1):164-173.
Publisher | Google Scholor - Gaudin, V., Vrain, T., Jouanin, L. (1994). Bacterial genes modifying hormonal balances in plants. Plant Physiology and Biochemistry, 32(1):11-29.
Publisher | Google Scholor - Gupta, S., Dikshit, A. K. (2010). Biopesticides: An eco-friendly approach for pest control. Journal of Biopesticides, 3(1):186-188.
Publisher | Google Scholor - Hofte, M., Seong, K. Y., Jurkevitch, E., Verstraete, W. (1991). Pyoverdin production by the plant growth beneficial Pseudomonas strain 7NSK2: Ecological significance in soil. Plant and Soil, 130(1):249-257.
Publisher | Google Scholor - Husson, O., Sarthou, J. P., Bousset, L., Ratnadass, A., Schmidt, H. P., et al. (2021). Soil health and sustainable agriculture: Role of microbial biofertilizers. Agronomy, 11(7):1351.
Publisher | Google Scholor - Husson, O., Sarthou, J. P., Bousset, L., Ratnadass, A., Schmidt, H. P., et al. (2021). Soil and plant health in relation to dynamic sustainment of Eh and pH homeostasis: A review. Plant and Soil, 466(1-2):391-447.
Publisher | Google Scholor - Itelima, J. U., Bang, W. J., Onyimba, I. A. (2018). A review: Biofertilizers as key players in sustainable agriculture. Biotechnology Research and Innovation, 2(1):1-7.
Publisher | Google Scholor - Jensen, H. L., Holm, L. (1975). Synergistic nitrogen fixation by mixed cultures of nitrogen-fixing and cellulolytic microorganisms. Plant and Soil, 43(1):119-127.
Publisher | Google Scholor - Jones, D. L., Darrah, P. R., Kochian, L. V. (1996). Critical evaluation of organic acid mediated iron dissolution in the rhizosphere and its potential role in root iron uptake. Plant and Soil, 180(1):57-66.
Publisher | Google Scholor - Kumar, A., Pawar, S. (2018). Impact of chemical fertilizers on agriculture. International Journal of Research in Applied Science and Engineering Technology, 6(3):432-435.
Publisher | Google Scholor - Kumar, S., Singh, A. (2015). Biopesticides: Present status and the future prospects. Journal of Fertilizers & Pesticides, 6(2):100-129.
Publisher | Google Scholor - Laishram, J., Saxena, K. G., Maikhuri, R. K., Rao, K. S. (2012). Soil quality and soil health: A review. Journal of Environmental Protection & Ecology, 38(1):19-37.
Publisher | Google Scholor - Liu, R. C., Xiao, Z. Y., Hashem, A., AbdAllah, E. F., Wu, Q. S. (2021). Mycorrhizal fungal diversity and its relationship with soil properties. Agriculture, 11(6):470.
Publisher | Google Scholor - Martinez, V., et al. (1988). Auxin and gibberellin production by Azotobacter vinelandii and Azospirillum brasilense isolated from tropical maize. Symbiosis, 6:45-57.
Publisher | Google Scholor - Mitra, D., Djebaili, R., Pellegrini, M., Mahakur, B., Sarker, A., et al. (2021). Arbuscular mycorrhizal symbiosis: Plant growth improvement and induction of resistance under stressful conditions. Journal of Plant Nutrition, 44(13):1993-2028.
Publisher | Google Scholor - Mohanty, P., Singh, P. K., Chakraborty, D., Mishra, S., Pattnaik, R. (2021). Insight into the role of PGPR in sustainable agriculture and environment. Frontiers in Sustainable Food Systems, 5:667150.
Publisher | Google Scholor - Montanarella, L., Pennock, D. J., McKenzie, N., Badraoui, M., Chude, V., et al. (2016). World’s soils are under threat. Soil, 2(1):79-82.
Publisher | Google Scholor - Nieto, K. F., Frankenberger, W. T. (1991). Influence of adenine, isopentyl alcohol and Azotobacter chroococcum on the vegetative growth of Zea mays. Plant and Soil, 135(1):213-221.
Publisher | Google Scholor - Okon, G., Okon, E., Glory, I. (2024). Effect of bioremediation on early seedling growth of Amaranthus hybridus L. grown on palm oil mill effluent polluted soil. International Journal of Biological Research, 2(2):84-86.
Publisher | Google Scholor - Ortiz, A., Sansinenea, E. (2021). Recent advancements for microorganisms and their natural compounds useful in agriculture. Applied Microbiology and Biotechnology, 105(3):891-897.
Publisher | Google Scholor - Ortiz-Castro, R., Valencia-Cantero, E., Lopez-Bucio, J. (2009). Plant growth promotion by Bacillus megaterium involves cytokinin signaling. Plant Signaling & Behavior, 4(8):713-715.
Publisher | Google Scholor - Paula, M. A., Reis, V. M., Dobereiner, J. (1991). Interactions of Glomus clarum with Acetobacter diazotrophicus in infection of sweet potato (Ipomoea batatas), sugarcane (Saccharum spp.), and sweet sorghum (Sorghum vulgare). Biology and Fertility of Soils, 11(2):111-115.
Publisher | Google Scholor - Perez-Montaño, F., Cynthia, A., Bellogín, R. A., Del Cerro, P., Espuny, M. R., et al. (2014). Plant growth promotion in cereal and leguminous agricultural important plants: From microorganism capacities to crop production. Microbiological Research, 169(5):325-336.
Publisher | Google Scholor - Prasad, K. (2025). Potential Impact of Green Biostimulants to Enhance Soil Health, Crop Physiology, Food Quality, and Agricultural Productivity Amidst Rising Global Population Demands. International Journal of Biomedical and Clinical Research, 4(3):1-21.
Publisher | Google Scholor - Prasad, K. (2024). Characterization, Selection and Evaluation of Temperature Tolerant Bradyrhizobium Japonicum Strains to Promote Soybean Cultivation in Tropical Soils Conditions. Sun Text Review of Biotechnology, 591:1-5.
Publisher | Google Scholor - Prasad, K. (2024). Occurrence and interactions of arbuscular mycorrhizal fungi (Rhizophagus fasciculatus) and rhizospheric fungi in Saccharum officinarum L. Tropical Plants, 3:e03.
Publisher | Google Scholor - Prasad, K. (2024). Arbuscular Mycorrhizal Fungi Advantageous Impact on Sustainable Agroecosystems and Bridge between Plants, Soils, and Humans Health. Journal of Life Sciences Research and Reviews, 2(3):1-4.
Publisher | Google Scholor - Prasad, K, Pandey, R. K. (2024). Reduce the Effects of Drought on Lycopersicon esculentum Growth and Productivity by Using Potential Combination of PGPR (Rhizophagus irregularis and Pseudomonas fluorescens). In: 9Th Asian PGPR India Chapter Beneficial Microbes for Sustainable Agriculture, Ponmurugan P, Anita A, Reedy MS (eds.), Excel India Publisher, New Delhi, 425-430.
Publisher | Google Scholor - Prasad, K., Rajasekaran, S., Pandey, R. K., Rajat, K. (2024). Multiple Functions of Microbes to Improve Food and Soil Nutrition in Support of Environment Management to Maintain Global Agricultural Practices. Journal of Energy and Environmental Science, 2(1):000114.
Publisher | Google Scholor - Prasad, K. (2022). Utilization of Siderophore Producing Plant Growth Promoting Rhizobacteria to Improve Crucial Nourishment and Management of Phytopathogen in Cash Crops for Sustainable Development. American Journal of Sciences and Engineering Research, 5(2):15-23.
Publisher | Google Scholor - Prasad, K. (2022). Productivity and Quality of Horticultural Crop Capsicum (Capsicum Annum L) Through Co-Inoculation of Novel Microbial Consortium Plant Growth Promoting Rhizobacteria, Glycoprotein Producing AM Fungi and Chemical Fertilizer under Low-Cost Protected Cultivation. Open Access Journal of Microbiology & Biotechnology. 7(2):1-18.
Publisher | Google Scholor - Prasad, K. (2022). Influence of PGPR, AM Fungi and Conventional Chemical Fertilizers Armament on Growth, Yield Quality, Nutrient’s translocations, and Quercetin Content in Onion Crop Cultivated in Semi-Arid Region of India. Open Access Journal of Microbiology & Biotechnology: 7(1):1-18.
Publisher | Google Scholor - Prasad, K. (2022). Potential Impression of Arbuscular Mycorrhizal Fungi on Agricultural Growth, Productivity, and Environment Toward Global Sustainable Development for Green Technology. In: Applied Mycology. Springer Nature.
Publisher | Google Scholor - Prasad, K. (2017). Biology, Diversity and Promising Role of Mycorrhizal Endophytes for Green Technology. In: Maheshwari, D. (eds) Endophytes: Biology and Biotechnology. Sustainable Development and Biodiversity, vol 15. Springer, Cham.
Publisher | Google Scholor - Riadh, K., Hajlaoui, H., Debez, A., Massoud, B., Abdelly, C. (2010). Role of organic and inorganic amendments in the phytoremediation of heavy metal-contaminated soils: A review. Environmental Chemistry Letters, 8(1):1-15.
Publisher | Google Scholor - Sarwar, M. (2015). Biopesticides: An effective and environmentally friendly insect pest’s inhibitor line of action. International Journal of Engineering and Advanced Research Technology, 1(1):10-15.
Publisher | Google Scholor - Schippers, B., Bakker, A. W., Bakker, A. H. M. (1987). Plant growth-promoting rhizobacteria as biological control agents. European Journal of Plant Pathology, 93(1):25-32.
Publisher | Google Scholor - Smith, F. A., Smith, S. E. (2011). Roles of arbuscular mycorrhizas in plant nutrition and growth: new paradigms from cellular to ecosystem scales. Annual Review of Plant Biology, 62:227-250.
Publisher | Google Scholor - Smith, S. E., Read, D. J. (2008). Mycorrhizal Symbiosis (3rd ed.). Academic Press.
Publisher | Google Scholor - Tarekegn, M. M., Salilih, F. Z., Ishetu, A. I. (2020). Microbes used as a tool for bioremediation of heavy metal from the environment. Cogent Food & Agriculture, 6(1):1783174.
Publisher | Google Scholor - Thakore, Y. (2006). The biopesticide market for global agricultural use. Industrial Biotechnology, 2(3):192-208.
Publisher | Google Scholor - Utkhede, R. S., Koch, C. A. (1991). Biological control of apple replant disease. Canadian Journal of Microbiology, 37(9):804-810.
Publisher | Google Scholor - Utkhede, R. S., Koch, C. A., Menzies, J. G. (1999). Rhizobacterial growth and yield promotion of cucumber plants inoculated with Pythium aphanidermatum. Canadian Journal of Plant Pathology, 21(3):265-271.
Publisher | Google Scholor - Van Peer, R., Niemann, G. J., Schippers, B. (1991). Induced resistance and phytoalexin accumulation in biological control of Fusarium wilt of carnationby Pseudomonas sp. strain WCS417r. Phytopathology, 81(7):728-734.
Publisher | Google Scholor - Vejan, P., Abdullah, R., Khadiran, T., Ismail, S., Nasrulhaq Boyce, A. (2016). Role of plant growth promoting rhizobacteria in agricultural sustainability-A review. Molecules, 21(5):573.
Publisher | Google Scholor - Vurukonda, S. S. K. P., Vardharajula, S., Shrivastava, M., SkZ, A. (2016). Enhancement of drought stress tolerance in crops by plant growth promoting rhizobacteria. Microbiological Research, 184:13-24.
Publisher | Google Scholor - Wang, L., Zhang, X., Liu, S., Li, X. (2023). Isolation and functional characterization of PGPR for potential application in crop production. Applied Microbiology and Biotechnology, 107(4):1459-1470.
Publisher | Google Scholor - Wenzel, W. W. (2009). Rhizosphere processes and management in plant-assisted bioremediation (phytoremediation) of soils. Plant and Soil, 321(1-2):385-408.
Publisher | Google Scholor - Wiren, N. V., Romheld, V., Morel, J. L., Guckert, A., Marschner, H. (1993). Influence of microorganisms on iron acquisition in maize. Soil Biology and Biochemistry, 25(3):371-376.
Publisher | Google Scholor - Yang, C. H., Crowley, D. E. (2000). Rhizosphere microbial community structure in relation to root location and iron nutrition status of maize. Journal of Environmental Quality, 29(3):678-684.
Publisher | Google Scholor - Zambrano-Mendoza, J. L., Sangoquiza-Caiza, C. A., Campaña-Cruz, D. F., Yánez-Guzmán, C. F. (2021). Use of biofertilizers in agricultural production. In Technology in agriculture. IntechOpen.
Publisher | Google Scholor - Zdor, R. E., Anderson, A. J. (1992). Influence of root colonizing bacteria on the growth and development of plants. Advances in Agronomy, 46:159-206.
Publisher | Google Scholor